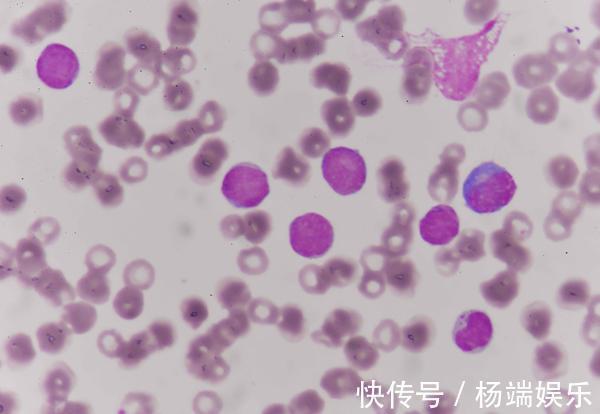
患者|癌症晚期是否要治,是不是不值得治医生说出了大实话!

患者|癌症晚期是否要治,是不是不值得治医生说出了大实话!
癌症的病发率近些年都呈现出了增长趋势,而且癌症的死亡率也一直居高不下!癌症是体内细胞变异、过度增殖后的产物,很多患者在癌症早期症状不够典型,甚至是毫无症状。而且,对于普通家庭来说,体检未被重视起来,小病小痛随便治治就好,这都给癌症留下了发展空间,直到晚期后癌症才被确诊。

文章插图
临床上有部分患者,在经过和癌症晚期苦苦抗争之后,不仅“倾家荡产”,最后留给家人的也仅仅是思念和巨额债务。所以,当面临癌症晚期时,患者和家属最大的疑问就是:到底癌症晚期,有没有必要倾家荡产的治疗。其实,这个问题要从两方面来看:

文章插图
1、癌症晚期是否要治,是不是不值得治?癌症可出现在身体任何一处有细胞的部位,所以临床上的癌症类型也多种多样。有部分癌症即便是走到了晚期,同样可存在长期生存、甚至是治愈的可能性。比如某些类型的淋巴瘤、恶性程度不高的肿瘤、某些儿童恶性肿瘤等。
文章插图
而且,伴有肝脏、肺部转移的大肠癌,转移病灶也可通过手术方式切除,然后再配合放化疗等方式,同样可存在长期生存的机会,非常值得进行治疗。另外,部分乳腺癌晚期、肺腺癌晚期等,尽管治愈的希望非常渺茫,但是临床可选择的治疗药物有很多,患者仍然能达到带瘤生存的状态,五六年、七八年、甚至是十多年,都有可能!

文章插图
即便是患者病情已经出现了全身的广泛转移,又或者是本身就是全身性的肿瘤,比如恶性白血病、恶性淋巴癌等,走到了不可挽回的地步。也不需要彻底放弃,可以采用温和的治疗手段,这能帮助患者减轻晚期时的痛苦,让患者在最后的生命段中,有尊严地离开。2、要不要倾家荡产的治疗上文中是从疾病本身进行分析的,接下来要考虑的则是患者的家庭经济方面。

文章插图
因为对癌症来说,治疗是医学问题,但却并不是纯粹的医疗问题,其还涉及到了其他的很多方面,比如经济和人性!虽说现在国家的医保政策正在逐步完善,但对于一个经济水平较差的家庭来说,仍然无力支付高昂的治疗费用,甚至需要借债进行治疗。这种情况,最终就需要取决于患者个人的选择,毕竟对待生命,每个人都有不同的看法,从本质上来说并没有标准答案。不过,对于治疗效果不好、已经失去治疗意义的患者来说,也应从理性的角度进行综合考虑。

文章插图
其实,从专业的医生角度来看,应让患者了解自身病情,并结合年龄、身体状况、经济情况等多方面来进行考虑。在有必要治疗的情况下,争取积极治疗,能增加自身治愈的可能。有时,即便是到了晚期,经过科学治疗也能尽可能控制病情发展,延长生命。不过,有时也需要患者面对现实,无畏的消耗和挣扎,反而是平添了自己的痛苦。对于已经失去治疗意义的患者来说,倒不如选择更好的“临终关怀”,让患者有尊严的离开,或许也是不错的做法。但是,这一切都要建立在患者个人意愿上,无论是医生或家属,都不应强求。
- 脂肪肝患者|脂肪肝能不药而愈?关于脂肪肝,这4个错误认知要避免
- 心脑血管|大荔中医医院脾胃肺病科“妙手回春”受到患者的称赞
- 救治|丨绿色通道丨多学科通力合作抢救无保护左主干前壁心梗患者
- 常崇旺|【视频回放】脑瘫患者常用外科术式及适应症
- 浴室里的“它”,可能是癌症帮凶,多数人洗澡时比较喜欢用
- 运动神经元患者案例分享
- 体内有癌,腰背先知晓?出现这2种标志,或是癌症“警告”?
- 人工心脏|山东首例人工心脏植入患者出院,需每天充电
- 守护|温暖“疫”线 | 迎难而上加班加点,医大二院全力守护透析患者“生命线”
- 香港|广州复大肿瘤医院案例966:香港胰腺癌患者赴广州就医重获新生
